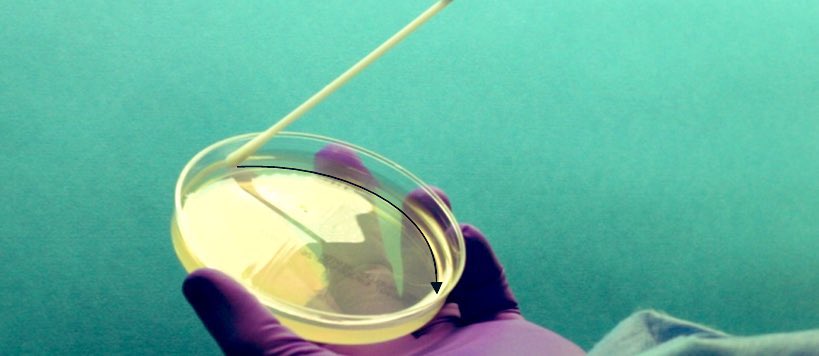
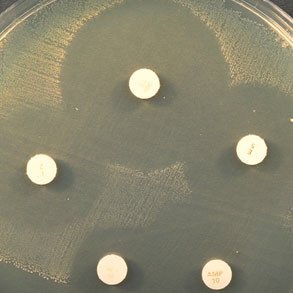

ثريد مبسط عن جهاز الـMicroscan Walkaway :
أحد الأجهزة الذي تقوم بوظيفة المولر هنتون أجار و إختبار الـAntibiotic Sensitivity Test (AST) و بشكل أدق و أسرع و بكميات أكثر بنفس الوقت.
أحد الأجهزة الذي تقوم بوظيفة المولر هنتون أجار و إختبار الـAntibiotic Sensitivity Test (AST) و بشكل أدق و أسرع و بكميات أكثر بنفس الوقت.
ثريد مبسط عن جهاز الـVITEK 2 Compact :
أحد الأجهزة الذي تقوم بوظيفة المولر هنتون أجار و إختبار الـAntibiotic Sensitivity Test (AST) و بشكل أدق و أسرع و بكميات أكثر بنفس الوقت.
أحد الأجهزة الذي تقوم بوظيفة المولر هنتون أجار و إختبار الـAntibiotic Sensitivity Test (AST) و بشكل أدق و أسرع و بكميات أكثر بنفس الوقت.
ان شاء الله استفدتم من الثريد و نلقاكم في مواضيع مستقبلية. 👍🏼✨
جاري تحميل الاقتراحات...